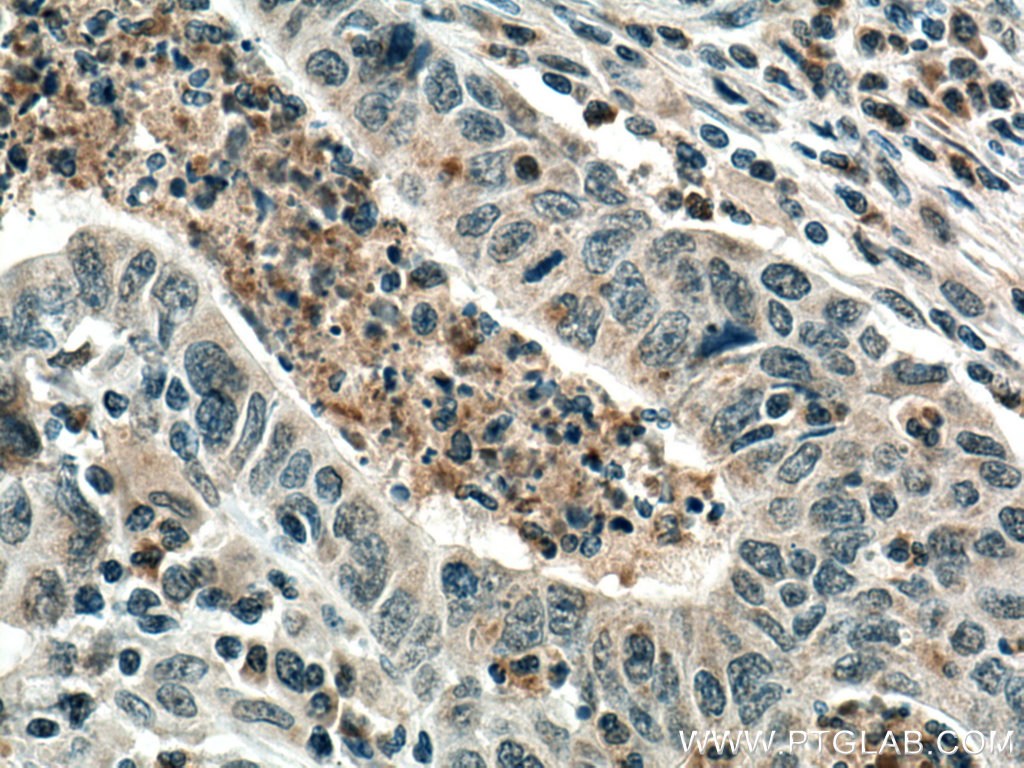

验证数据展示
经过测试的应用
| Positive WB detected in | HepG2 cells, rat brain tissue, L02 cells, 4T1 cells |
| Positive IHC detected in | human colon cancer tissue Note: suggested antigen retrieval with TE buffer pH 9.0; (*) Alternatively, antigen retrieval may be performed with citrate buffer pH 6.0 |
推荐稀释比
| 应用 | 推荐稀释比 |
|---|---|
| Western Blot (WB) | WB : 1:500-1:2000 |
| Immunohistochemistry (IHC) | IHC : 1:250-1:1000 |
| It is recommended that this reagent should be titrated in each testing system to obtain optimal results. | |
| Sample-dependent, Check data in validation data gallery. | |
产品信息
55206-1-AP targets PCSK9 in WB, IHC, IF, ChIP, ELISA applications and shows reactivity with human, mouse, rat samples.
| 经测试应用 | WB, IHC, ELISA Application Description |
| 文献引用应用 | WB, IHC, IF, ChIP |
| 经测试反应性 | human, mouse, rat |
| 文献引用反应性 | human, mouse, rat, hamster |
| 免疫原 |
Peptide 种属同源性预测 |
| 宿主/亚型 | Rabbit / IgG |
| 抗体类别 | Polyclonal |
| 产品类型 | Antibody |
| 全称 | proprotein convertase subtilisin/kexin type 9 |
| 别名 | EC:3.4.21.-, FH3, HCHOLA3, LDLCQ1, NARC 1 |
| 计算分子量 | 74 kDa |
| 观测分子量 | 58-62 kDa, 72-78 kDa |
| GenBank蛋白编号 | NM_174936 |
| 基因名称 | PCSK9 |
| Gene ID (NCBI) | 255738 |
| RRID | AB_10918272 |
| 偶联类型 | Unconjugated |
| 形式 | Liquid |
| 纯化方式 | Antigen affinity purification |
| UNIPROT ID | Q8NBP7 |
| 储存缓冲液 | PBS with 0.02% sodium azide and 50% glycerol, pH 7.3. |
| 储存条件 | Store at -20°C. Stable for one year after shipment. Aliquoting is unnecessary for -20oC storage. |
背景介绍
Proprotein convertase subtilisin/kexin type 9 (PCSK9) is a crucial protein governing the circulating levels of low density lipoprotein-cholesterol (LDL-C), by virtue of its pivotal role in the degradation of the LDL receptor (LDLR). PCSK9 is expressed in the kidney and lung. It is synthesized as a 72 kDa immature precursor that undergoes autocatalytic cleavage in the endoplasmic reticulum to generate a 63 kDa mature protein. The cleaved N-terminal fragment remains associated with the mature protein and is necessary for its secretion, allowing it to circulate in the blood. The ability of PCSK9 to regulate a diverse group of cell-surface proteins hinted that it might also be able to influence additional membrane proteins that are important in anti-tumour immune responses. Targeting PCSK9 to treat cancer is also attractive because two neutralizing antibodies against it, evolocumab and alirocumab, have already been approved for human clinical use to lower cholesterol levels. (PMID: 30522786, PMID: 22493497)
实验方案
| Product Specific Protocols | |
|---|---|
| IHC protocol for PCSK9 antibody 55206-1-AP | Download protocol |
| WB protocol for PCSK9 antibody 55206-1-AP | Download protocol |
| Standard Protocols | |
|---|---|
| Click here to view our Standard Protocols |
发表文章
| Species | Application | Title |
|---|---|---|
J Nanobiotechnology Evolocumab loaded Bio-Liposomes for efficient atherosclerosis therapy | ||
Biomed Pharmacother Berberine is a potential alternative for metformin with good regulatory effect on lipids in treating metabolic diseases | ||
Int J Mol Sci Diverse Effects of Cilostazol on Proprotein Convertase Subtilisin/Kexin Type 9 between Obesity and Non-Obesity | ||
Int J Mol Sci Renal Ischemia/Reperfusion Early Induces Myostatin and PCSK9 Expression in Rat Kidneys and HK-2 Cells. |